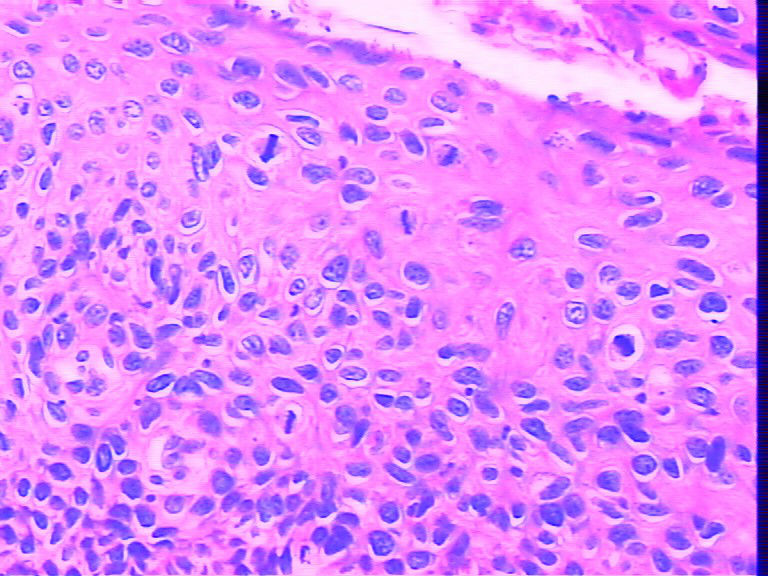
已解决：宫颈有明确的HPV感染，CIN等级是否可以降一级图5

| 图片: | |
|---|---|
| 名称: | |
| 描述: | |
- 已解决:宫颈有明确的HPV感染,CIN等级是否可以降一级
-
最终这个病理报告了CIN II级伴HPV感染,咨询了多人不认同伴有HPV可以降级CIN!CIN I II III从病因学上讲都是HPV引起的,所以镜下见不见HPV的挖空样改变没有意义,病原体是肯定看不到的!在此谢谢大家的回帖!
宫颈有明确的HPV感染,CIN等级是否可以降一级?
请问有没有这种说法?就拿下面那副图看看,可以打到cin II ,但听说套用这种说法,打CIN I 比较好,是不是真的这样?

名称:全层宫颈
描述:1

名称:病变超过2/3,够II级
描述:2

标签:
-
本帖最后由 robot2009 于 2011-11-16 15:54:20 编辑
×参考诊断
-
yangzhijun 离线
- 帖子:84
- 粉蓝豆:2
- 经验:86
- 注册时间:2010-05-13
- 加关注 | 发消息
-
wangqiupeng 离线
- 帖子:148
- 粉蓝豆:1
- 经验:492
- 注册时间:2010-05-05
- 加关注 | 发消息
-
1394361892 离线
- 帖子:655
- 粉蓝豆:12
- 经验:1275
- 注册时间:2011-09-04
- 加关注 | 发消息






















